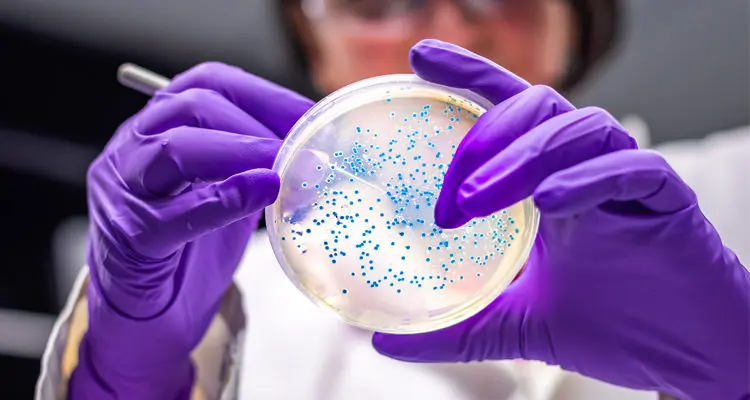

Behavioral Health Institute at Harborview
Help increase access to early, effective behavioral healthcare in our region and accelerate mental health and addiction treatment.

Help increase access to early, effective behavioral healthcare in our region and accelerate mental health and addiction treatment.

Advance groundbreaking research in precision medicine, genomics and data science that will improve diagnostics and treatments for people with cancer, Alzheimer’s and other diseases.

Fast-track vaccine research and development for breast, colon, ovarian, prostate, pancreatic, sarcoma, lung and bladder cancers to both treat and prevent cancer and its recurrence.

Help fast-track discoveries in the molecular basis of cardiovascular disease, develop innovative new therapies and train tomorrow’s physicians and researchers.

Accelerate the development of 3D printing and virtual reality to diagnose and treat heart disease, heart failure and heart rhythm disorders.

Help transform mental health and addiction care in our state, advance innovative new treatments and programs, and train the next generation of health care professionals.
Advance microbiome research; support researchers and clinicians’ scientific collaboration; and educate the community about the importance of the microbiome — and gut health — in maintaining a healthy lifestyle.

Unlock the power of big data by translating discoveries in artificial intelligence and machine learning into groundbreaking care for people with eye disease.

Help us get closer to a future free of diabetes and related metabolic disorders.

Accelerate solutions to improve health for the millions of people affected by mental health, substance use and other brain health disorders.

Help our clinicians provide groundbreaking treatments, advanced surgeries and world-class care for the most complex heart problems.

Support the IHDD’s research, clinical care, education and advocacy and help create a brighter future for people with intellectual and developmental disabilities.

Support data analysis on the world’s most important health problems — including COVID-19 — that directly informs global public health strategies.

Catalyze breakthroughs that use computer-designed synthetic proteins to address 21st-century challenges in medicine, from treating cancer to developing COVID-19 vaccines.

Help our scientists and researchers make medical breakthroughs that end chronic diseases like heart disease, Alzheimer’s, diabetes, kidney disease and cancer.

Help advance lifesaving new treatments and technologies — like a wearable artificial kidney — that improve the health and well-being of people with kidney disease.

Fast-track treatments and innovative community programs for patients with memory loss and their caregivers at one of the country’s best centers for Alzheimer’s disease research.

Help advance our whole-person approach to clinical care, from diagnosis to treatment and rehabilitation; train tomorrow’s medical leaders; and connect patients with the latest clinical trials.

Help our region’s top researchers and physicians bring hope to patients seeking answers and lifesaving treatments for brain and nervous system disorders.

Help us advance critical initiatives to eliminate healthcare disparities and increase recruitment and retention of faculty and students from communities that are underrepresented in medicine.

Power innovative clinician-led projects designed to improve patient care and outcomes.

Advance programs, research and advocacy that lead to safer sports and inspire a lifelong love of physical activity.

Help create the Women’s Heart Health Initiative to catalyze a new era in cardiology and significantly reduce heart disease for everyone.
Your visionary gift to UW Medicine gets us closer to finding bold solutions to today’s biggest challenges in medicine. See how your generosity can be a game-changer.

The AHEAD program helps emerging adults with diabetes achieve lifelong health.
Read Story
The Cancer Vaccine Institute at UW Medicine is harnessing the immune system to treat and prevent cancer.
Read Story
Recognizing Jon Fine’s lasting impact on health with the 2025 Ragen Volunteer Service Award.
Read Story
Why Andrew Trister, MD, PhD, Res. ’10, Chief Res. ’14, is driven to bridge the gap between technology and medicine.
Read Story
How donor-supported research at UW Medicine is changing lives for patients with Alzheimer’s disease and dementia.
Read Story
Harborview Medical Center offers the best medical care for our region — and beyond.
Read Story
It takes a multidisciplinary team to find the right treatment for epilepsy — which is why Kathleen Simpson turned to UW Medicine’s Regional Epilepsy Center at Harborview.
Read Story
Life-threatening strokes can happen without warning. UW Medicine’s Neurosciences Institute at Harborview Medical Center is ready 24/7 to respond.
Read Story
At the Seattle Hub for Synthetic Biology (SeaHub), a new research collaboration, UW Medicine researchers will use groundbreaking technology to record cellular changes over time.
Read Story
UW Medicine’s Neurosciences Institute provides exceptional care and conducts groundbreaking research to better understand and treat complex neurological issues.
Read Story